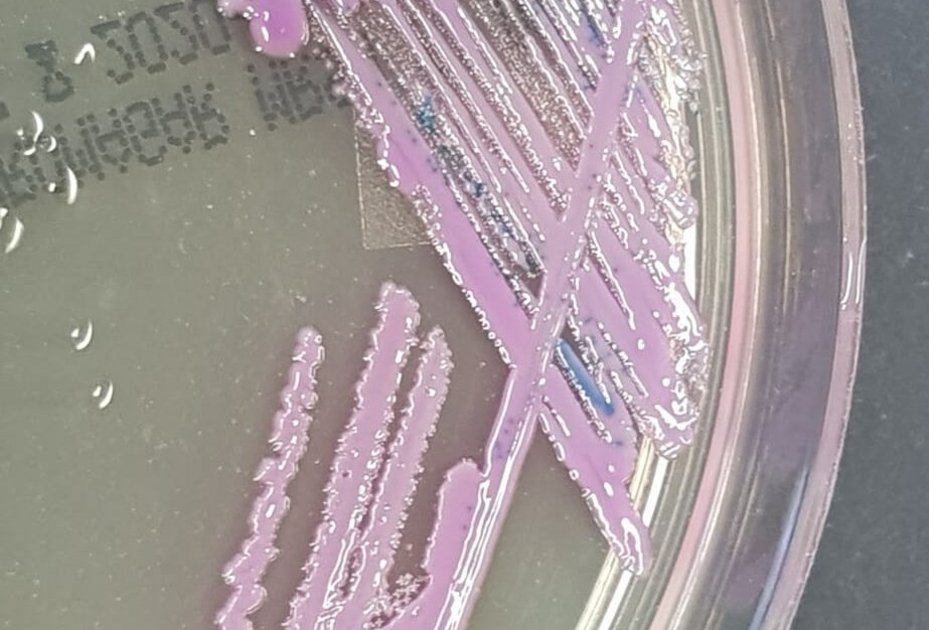

- Startseite /
- Forschung /
- Aktuelles aus der Forschung
- One Health: Antibiotika-Resistenzen gefährden Mensch und Hund
Forschung
One Health: Antibiotika-Resistenzen gefährden Mensch und Hund
Angesichts der großen Nähe von Mensch und Tier ist die Verbreitung von Antibiotika-Resistenzen eine Bedrohung der öffentlichen Gesundheit. Und sie erfordert ein gemeinsames und sektorübergreifendes Vorgehen von Human- und Veterinärmedizin an den Schnittstellen zwischen Mensch, Tier und Umwelt. Diese Notwendigkeit unterstreicht eine aktuelle Studie unter Leitung der Veterinärmedizinischen Universität Wien. Die Forschungsarbeit liefert die erste detaillierte und umfassende Charakterisierung von Staphylococcus aureus aus Hunden in Ruanda – und weist außerdem menschliche Ursprünge der Bakterien nach.
Die Studie ist das jüngste Ergebnis einer langjährigen Zusammenarbeit mit der University of Rwanda und dem New Vision Veterinary Hospital (NVVH) in Ruanda. Zuvor haben bereits Studien zu Wiederkäuern auf die Problematik der von Mensch zu Tier und umgekehrt überspringenden Antibiotika-Resistenzen hingewiesen. Aus diesem Grund ist es laut den Forscher:innen wichtig, nationale und globale „One Health“-Überwachungsprogramme für Antibiotika-Resistenzen einzurichten, um die Antibiotika-Resistenz-Krise in der Human- und Veterinärmedizin zu bewältigen.
In der in „Letters in Applied Microbiology“ veröffentlichten Studie „Staphylococcus aureus in Rwandan dogs predominantly representing human-associated lineages“* wurde die Übertragung von Staphylococcus (S.) aureus aus der Nase und den Ohren von ruandischen Hunden und Katzen untersucht. Das internationale Forschungsteam unter Leitung der Vetmeduni konnte dabei 65 S. aureus-Isolate nachweisen, die alle aus der Nasenhöhle von Hunden stammten. „Wir stellten dabei eine Resistenz gegen Penicillin, Penicillin / Erythromycin / Clindamycin, Penicillin / Tetracyclin und Tetracyclin fest“, erklärt Studien-Letztautor Igor Loncaric vom Zentrum für Pathobiologie der Vetmeduni.
Erhebliches Risiko für die öffentliche Gesundheit
Die Mehrheit der Isolate gehörte zu den vorwiegend mit dem Menschen assoziierten klonalen Linien von S. aureus. „Die Identifizierung von mit dem Menschen assoziierten klonalen Komplexen (CCs) unterstreicht das Potenzial für eine bidirektionale Übertragung zwischen verschiedenen Spezies, was ein erhebliches Risiko für die öffentliche Gesundheit darstellt“, betont Igor Loncaric. „Allerdings haben wir bisher keine Ahnung, warum Hunde solche Bakterien beherbergen, weil das Verhältnis zwischen Mensch und Hund ist ganz anders als hier“, identifiziert der Wissenschafter weiteren Forschungsbedarf. In Verbindung mit der begrenzten Verfügbarkeit von S.aureus-Daten aus der Humanmedizin in Ruanda zeigen die Studienergebnisse laut den Forscher:innen die Bedeutung von Hygienemaßnahmen und die Notwendigkeit eines strengen One-Health-Überwachungsprogramms an der Schnittstelle von Haustieren und Menschen.
Gefährliche Antibiotika-Resistenzen bei Kühen, Ziegen und Schafen in Ruanda erfordern nationale und globale „One Health“-Überwachungsprogramme
Die Bedeutung von One Health zum Schutz von Mensch und Tier vor Antibiotika-Resistenzen illustriert auch die kürzlich erschienene, von der Vetmeduni geleitete Studie „Survey in ruminants from Rwanda revealed high diversity and prevalence of extended-spectrum cephalosporin-resistant Enterobacterales“**. Die Untersuchung von Wiederkäuern in Ruanda ergab dabei eine hohe Diversität und Prävalenz von gegen Cephalosporine mit erweitertem Spektrum resistenten Enterobacterales („Enterobakterien“). „Angesichts der großen Nähe von Wiederkäuern und Menschen in Ruanda, ist dieses Ergebnis vor allem deshalb wichtig, da antimikrobielle Resistenzen (AMR) bei Enterobacterales eine erhebliche Bedrohung für die Gesundheit von Mensch und Tier und ein sozioökonomisches Problem darstellen. In diesem Zusammenhang sind Enterobacterales, vor allem Escherichia coli, zu einem der wichtigsten Indikatoren für die Abschätzung der Belastung durch AMR bei Tieren im Rahmen des ‚One Health‘-Ansatzes geworden“, so Igor Loncaric.
Vielfalt von S. aureus bei Mastitis im Blick
Eine weitere aktuelle Studie der Forschungsgruppe um Igor Loncaric, veröffentlicht im Journal of Applied Microbiology ("Diversity of Staphylococcus aureus isolated from nares of ruminants"), untersuchte Nasenabstriche von Wiederkäuern, um den Zusammenhang zwischen human- und Mastitis-assoziierten Staphylokokken besser zu verstehen. Diese Untersuchung ist eine Fortsetzung früherer Studien zur Mastitis, der ökonomisch wichtigsten Rinderkrankheit in Ruanda. Dazu gehören die Veröffentlichungen „Diversity of Staphylococcus aureus associated with mastitis from dairy cows in Rwanda“ (Journal of Global Antimicrobial Resistance, 2024) und „Characterization of Antibiotic and Biocide Resistance Genes and Virulence Factors of Staphylococcus Species Associated with Bovine Mastitis in Rwanda“ (Antibiotics, 2019). Ziel der Forscher:innen war es hier, die Vielfalt von S. aureus und anderen Staphylokokken aus Mastitis-Milchproben von Kühen in Ruanda zu untersuchen. Dabei wurden S. aureus-Isolate mit Resistenzen gegen Penicillin, Tetracyclin und weitere Antibiotika sowie multi-resistente Koagulase-negative Staphylokokken entdeckt, wobei sowohl human-assoziierte als auch für Ruanda typische bovine klonale Linien beobachtet wurden.
Langjährige Forschungszusammenarbeit der Vetmeduni in Ruanda
Die Studien sind die jüngsten Forschungsergebnisse einer langjährigen Zusammenarbeit der Vetmeduni mit der University of Rwanda (UR) und dem mit österreichischer Unterstützung eingerichteten New Vision Veterinary Hospital (NVVH) in Musanze (Ruanda). Igor Loncaric ist an dieser Zusammenarbeit seit vielen Jahren beteiligt und hat aus dieser Kooperation heraus bereits eine Reihe an Forschungsarbeiten durchgeführt und zahlreiche Studierende sowohl von der Vetmeduni als auch Studierende aus Ruanda angeleitet.
In der Kooperation ist Loncaric vor allem für Wissenstransfer und Forschung verantwortlich, insbesondere was die Mikrobiologie angeht. „Bisher haben wir in Kooperation mit weiteren Forschungseinrichtungen wie der MedUni Innsbruck (Werner Ruppitsch) und der AGES (Adriana Cabal Rosel) aus Österreich sowie der FU Berlin (Stefan Schwarz, Andrea Feßler) und der ipht Jena (Ralf Ehricht, Stefan Monecke) gemeinsam mit Kolleg:innen aus Ruanda eine Reihe wichtiger Publikationen veröffentlicht. Weitere Studien sind in Arbeit. Dabei beschäftigen wir uns vor allem mit antibiotikaresistenten Bakterien und potenziell human- als auch tierpathogenen Bakterien. Während wir uns mit Bakterien beschäftigen, wird der organisatorische Teil von Kollegin Ursula Schober von unserem Büro für Internationale Beziehungen und Kollegen Otto Fischer (Gründer von NVVH und der NGO Veterinärprojekt Ruanda) maßgeblich unterstützt, denn ohne unseren Partner:innen wären diese Forschungs- und Lehraktivtäten nicht möglich“, so Igor Loncaric.
Wissenschaftliche Studien:
* Staphylococcus aureus in Rwandan dogs predominantly representing human-associated lineages | Letters in Applied Microbiology | Oxford Academic
** Survey in ruminants from Rwanda revealed high diversity and prevalence of extended-spectrum cephalosporin-resistant Enterobacterales | BMC Veterinary Research
Rückfragehinweis:
Priv. Doz. Dr. Igor Loncaric
Zentrum für Pathobiologie
Veterinärmedizinische Universität Wien (Vetmeduni)
igor.loncaric@vetmeduni.ac.at





